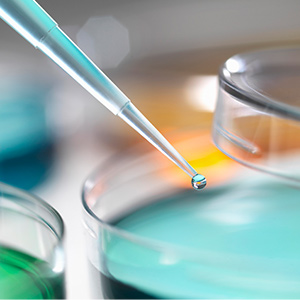

?
??????? 樣品過濾是制備色譜分析樣品的關(guān)鍵步驟。實(shí)驗(yàn)前如果不過濾樣品會(huì)導(dǎo)致色譜柱篩板堵塞等問題,從而導(dǎo)致背壓增高和色譜柱性能下降。最終,這會(huì)增加花在色譜儀故障排除和維護(hù)上的時(shí)間,浪費(fèi)時(shí)間也增加科研人員的工作量。
??????? 對(duì)于大多數(shù)類型的樣品,過濾處理相對(duì)比較簡(jiǎn)單。在進(jìn)樣前用溶劑進(jìn)樣口過濾器對(duì)流動(dòng)相過濾。這一步也非常重要,用色譜過濾頭可有效濾除流動(dòng)相中的固體顆粒雜質(zhì);未經(jīng)過濾的溶劑或溶劑瓶中生長(zhǎng)的微生物都會(huì)降低液相色譜柱和泵的性能。使用一段時(shí)間后需要定期清洗或更換溶劑入口濾頭。
??????? 在食品和飲料行業(yè)分析時(shí),一些濃糖漿、果肉汁和脂肪等具有粘性或含有大量顆粒物樣品是比較難過濾的。并且如果你的樣品含有玉米淀粉、糖漿、大豆、蔗糖或水果添加劑等成分,使用標(biāo)準(zhǔn)注射器過濾器也是一項(xiàng)挑戰(zhàn)。
??????? 過濾具有粘性樣品時(shí)需要注意什么問題?手推動(dòng)粘性樣品通過注射器過濾器時(shí),需要用手大力推,需要使用多個(gè)注射器,降低效率;由于玻璃料堵塞可能需要增加泵壓力;分析容易出現(xiàn)肩峰或分裂色譜峰等等。
??????? 如何更有效地過濾粘性樣品?
??????? 可以用帶有預(yù)過濾疊層的針頭式過濾器,疊層由超細(xì)纖維組成,可在較大顆粒到達(dá)指定孔徑的過濾器之前將其攔截捕獲。這能較高效率處理冗長(zhǎng)的樣品量。
??????? 選擇具有正確化學(xué)相容性的過濾器也很重要。例如,對(duì)水性樣品使用疏水性材料會(huì)導(dǎo)致背壓積聚。選擇錯(cuò)誤的膜會(huì)導(dǎo)致其他性能問題。
???????? 恒譜生總結(jié)了以下幾個(gè)HPLC、UHPLC 樣品制備注意事項(xiàng),供大家參考:
??????? 對(duì)注射器最好施加均勻適度的壓力,以確保產(chǎn)生一致的樣品。如果背壓開始產(chǎn)生明顯阻力,請(qǐng)檢查您的過濾器是否有問題。
??????? 如果您遇到過濾背壓增高、膜堵塞或由于未過濾的顆粒進(jìn)入進(jìn)樣器而導(dǎo)致色譜柱性能下降,請(qǐng)考慮使用預(yù)過濾疊層。色譜柱性能下降是需要重點(diǎn)關(guān)注的問題,平常維護(hù)也需要用心。在柱前添加一個(gè)保護(hù)柱相當(dāng)于在色譜柱前增加了一段額外的填料,起到了保護(hù)整個(gè)色譜柱的作用。如果在意增加色譜保護(hù)柱可能會(huì)引起死體積增大,可以采用恒譜生直聯(lián)式保護(hù)柱套,它可與色譜柱入口直接相連,手緊直聯(lián)不需要其他的連接管路,也可達(dá)到優(yōu)異的色譜性能,不會(huì)增加死體積。
??????? 如果使用注射器時(shí)有強(qiáng)烈的阻力,請(qǐng)勿強(qiáng)行讓樣品通過。這樣做可能會(huì)導(dǎo)致不必要的問題,甚至可能導(dǎo)致過濾器泄漏。
??????? 當(dāng)您有大量樣品時(shí),不要自動(dòng)選擇窄直徑過濾器。請(qǐng)選擇適合體積的直徑。
??????? 想了解更多色譜相關(guān)知識(shí),關(guān)注恒譜生,為您解憂!
發(fā)布于: 2021-12-17